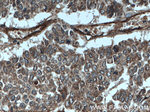
ITGAV Antibody in Immunohistochemistry (Paraffin) (IHC (P))
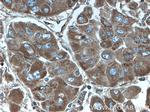
ITGAV Antibody in Immunohistochemistry (Paraffin) (IHC (P))

Search
Proteintech
ITGAV Polyclonal Antibody
{{$productOrderCtrl.translations['antibody.pdp.commerceCard.promotion.promotions']}}
{{$productOrderCtrl.translations['antibody.pdp.commerceCard.promotion.viewpromo']}}
{{$productOrderCtrl.translations['antibody.pdp.commerceCard.promotion.promocode']}}: {{promo.promoCode}} {{promo.promoTitle}} {{promo.promoDescription}}. {{$productOrderCtrl.translations['antibody.pdp.commerceCard.promotion.learnmore']}}
产品信息
27096-1-AP
种属反应
宿主/亚型
分类
类型
抗原
偶联物
形式
浓度
规格
纯化类型
保存液
内含物
保存条件
运输条件
产品详细信息
Immunogen sequence: SFSKAMLHL QWPYKYNNNT LLYILHYDID GPMNCTSDME INPLRIKISS LQTTEKNDTV AGQGERDHLI TKRDLALSEG DIHTLGCGVA QCLKIVCQ (819-915 aa encoded by BC136442)
靶标信息
ITAGV encodes integrin alpha chain V. Integrins are heterodimeric integral membrane proteins composed of an alpha chain and a beta chain. The I-domain containing integrin alpha V undergoes post-translational cleavage to yield disulfide-linked heavy and light chains, that combine with multiple integrin beta chains to form different integrins. Among the known associating beta chains (beta chains 1,3,5,6, and 8, 'ITGB1', 'ITGB3', 'ITGB5', 'ITGB6', and 'ITGB8'), each can interact with extracellular matrix ligands, the alpha V beta 3 integrin, perhaps the most studied of these, is referred to as the Vitronectin receptor (VNR). In addition to adhesion, many integrins are known to facilitate signal transduction. The ITGB3 protein product is the integrin beta chain beta 3. Integrins are integral cell-surface proteins composed of an alpha chain and a beta chain. A given chain may combine with multiple partners resulting in different integrins. Integrin beta 3 is found along with the alpha IIb chain in platelets. Integrins are known to participate in cell adhesion as well as cell-surface mediated signalling.
仅用于科研。不用于诊断过程。未经明确授权不得转售。
生物信息学
蛋白别名: antigen identified by monoclonal antibody L230; CD51; Integrin alpha-V; integrin alphaVbeta3; integrin, alpha V (vitronectin receptor, alpha polypeptide, antigen CD51); unnamed protein product; vitronectin alpha subunit precursor; Vitronectin receptor; Vitronectin receptor subunit alpha
基因别名: CD51; ITGAV; MSK8; VNRA; VTNR
UniProt ID: (Human) P06756
Entrez Gene ID: (Human) 3685